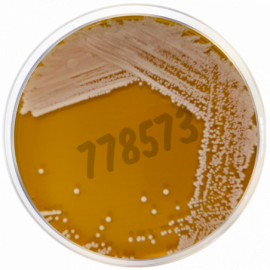
Milieu déshydraté gelose base hc 500 g

Microbiologie
9089 produits - Trié par pertinence
Gélose de Mac Conkey BAC Ph. Eur. ISO-21567 500 g
Réf. UGAP : 3712577 Réf. constructeur : AGMC-IEP-500
Kit coloration rapide de Weigert Van Gieson, 100 tests x 1
Réf. UGAP : 3918867 Réf. constructeur : DK14136
Milieu déshydraté bouillon pour bacteries nocives biere 500g
Réf. UGAP : 3658592 Réf. constructeur : 1440